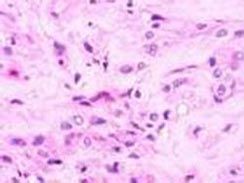
上皮樣血管內皮細胞瘤

病因
上皮樣血管內皮細胞瘤
上皮樣血管內皮細胞瘤臨床表現
該病為多灶性血管腫瘤,可侵襲軟組織和肺、肝、骨等器官。皮膚損害罕見,呈單發或多發性緩慢生成的丘疹或結節。好發於上肢或下肢,多見於25歲前的男性。皮膚損害常與其下方的骨受累伴發,自覺症狀從無症狀到伴發嚴重灼熱痛。
檢查
組織病理檢查可見擴張的血管和梭形細胞兩種組織結構,可見細胞多形性和核分裂象。網硬蛋白染色見個別細胞和成群細胞外方繞有網狀纖維。免疫組化檢查,第8因子相關抗原和荊豆植物血凝素陽性。上皮膜抗原和細胞角蛋白染色通常為陰性。
診斷
根據臨床表現以多灶性血管腫瘤、出現皮膚損害罕見、結合組織病理檢查即可診斷。
治療
廣泛切除。少數轉移者可用化療或放療,或二者聯合套用。

